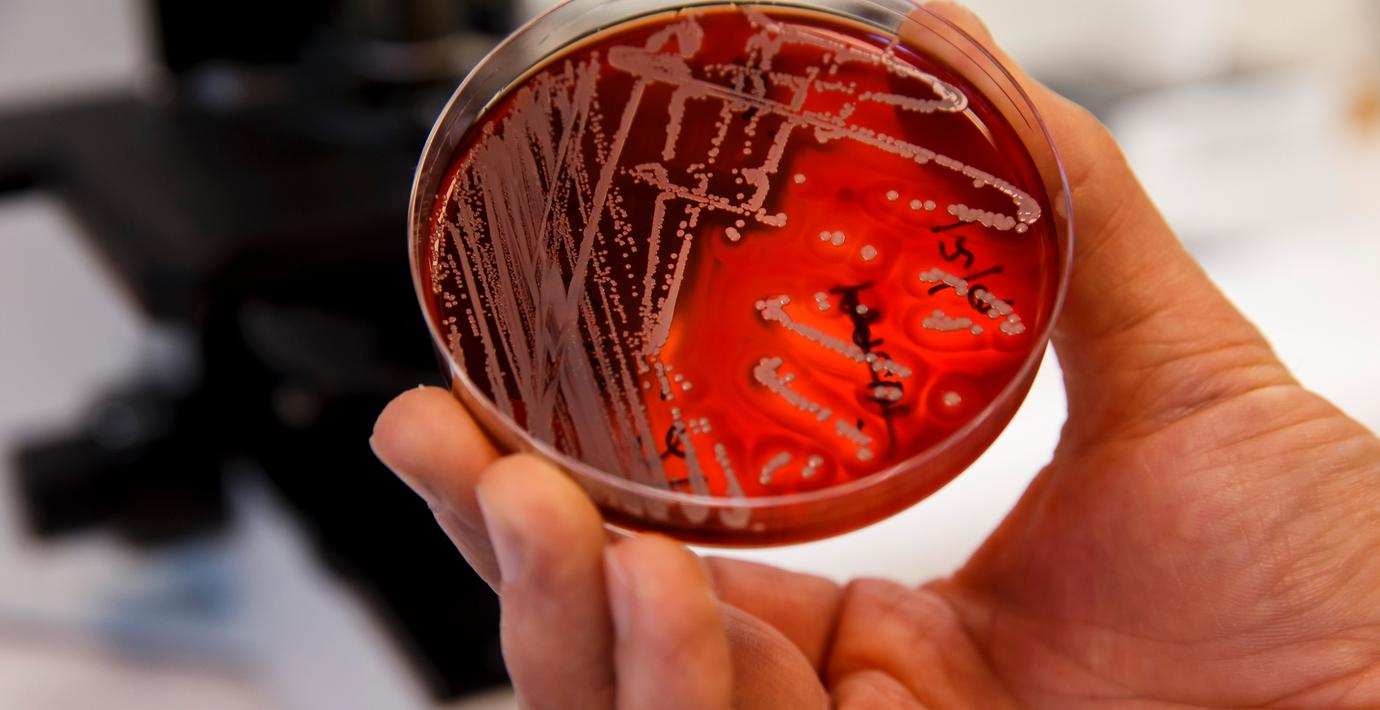

WHO: Lär av covid när det gäller resistenta bakterier
Världen bör ta lärdom av coronapandemin när det gäller kampen mot antibiotikaresistenta bakterier. Det anser Världshälsoorganisationen (WHO), rapporterar AFP.
Enligt WHO har pandemin gjort att människor har fått upp ögonen för hur snabbt smittsamma sjukdomar kan spridas, men också visat hur snabbt det går att nå framsteg i kampen mot en sjukdom om den politiska viljan finns.
”Tillfället som uppstått till följd av pandemin måste tas tillvara för att lyfta fram behovet av hållbara satsningar på utveckling och forskning kring ny, effektiv antibiotika”, skriver Haileyesus Getahun som leder WHO:s division för arbete mot antibiotikaresistens.
Omni är politiskt obundna och oberoende. Vi strävar efter att ge fler perspektiv på nyheterna. Har du frågor eller synpunkter kring vår rapportering? Kontakta redaktionen



